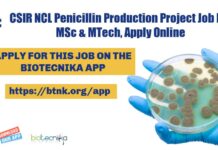
CSIR NCL Penicillin Production Project Job For MSc & MTech, Apply Online CSIR-NCL Pune Associate

Evaluation of Drugs Project Recruitment at ICMR-NIRRH, Apply Online
NIRRH Project Vacancy - Life Sciences / Microbiology/ Biotech Apply
NIRRH Project Vacancy - Life Sciences / Microbiology/ Biotech Apply. NIRRH recruitment for MSc candidates....
AIIMS Bhubaneswar Bioinformatics Job With Rs. 60,000 pm Pay
AIIMS Bhubaneswar Bioinformatics Job With Rs. 60,000 pm Pay
AIIMS Bhubaneswar Bioinformatics Job With Rs. 60,000 pm Pay. PhD Bioinformatics Post Doctoral Fellow (PDF) Job....
Govt HP Forest Assistant Zoo Biologist Recruitment For Life Sciences & Zoology
Himachal Pradesh Forest Dept Recruitment - Life Sciences & Zoology Apply
Himachal Pradesh Forest Dept Recruitment - Life Sciences & Zoology Apply. Government Zoology, Life...
Pachhunga University College, Project Assistant Recruitment For MSc Life Sciences
Pachhunga University College, Project Assistant Recruitment For MSc
Pachhunga University College, Project Assistant Recruitment For MSc. MSc Life Sciences, Microbiology, Biotechnology, Biochemistry, Zoology, Molecular and...
Something GRAND is Coming at BioTecNika
Something GRAND is Coming at BioTecNika
Are you ready for the next MEGA Announcement On Biotecnika?
Get ready!
This October is going to be Rocktober
Something GRAND...
Bioinformatics Project Scientist Job at Punjab Agricultural University
Bioinformatics Project Scientist Job at Punjab Agricultural University
Bioinformatics Project Scientist Job at Punjab Agricultural University. PhD in Biotechnology/ Bioinformatics/ System Biology and Bioinformatics/ Computational...
HPCL Biofuels Limited Biotech Recruitment, Applications Invited
HPCL Biofuels Limited Recruitment, Applications Invited
HPCL Biofuels Limited Recruitment, Applications Invited. Hindustan Petroleum Corporation Limited Biofuels Limited Job Openings. Interested and eligible applicants can...
ICGEB-JNU Ph.D. Programme 2021 Admission, Online Application Process
ICGEB-JNU PhD Programme 2021 Admission, Online Application Process
ICGEB-JNU PhD Programme 2021 Admission, Online Application Process. PhD Admissions 2021. ICGEB-JNU PhD Admission 2021. Interested and...
CSIR NCL Penicillin Production Project Job For MSc & MTech, Apply Online
CSIR-NCL Pune Associate Jobs, Online Application Process
CSIR-NCL Pune Associate Jobs, Online Application Process. NCL Pune is hiring MSc, BE, BTech & MTech Natural Sciences...
Govt SSC Staff Selection Commission Recruitment 2021, Online Application Process
SSC Staff Selection Commission Recruitment 2021, Apply Online
SSC Staff Selection Commission Recruitment 2021, Apply Online. MSc, BTech and BSc candidates apply. Botany, Zoology, Agriculture,...
CDFD Project Associate Recruitment, Applications Invited From MSc & BTech
CDFD Project Associate Recruitment, Applications Invited From MSc & BTech
CDFD Project Associate Recruitment, Applications Invited From MSc & BTech. MSc biochemistry, biotechnology, bioinformatics are...
Biotecnika Times Newsletter 28.09.2021 Pepsi Recruitment, DHR Women Scientists Fellowship
Biotecnika Times - Pepsi Recruitment, DHR Women Scientists Fellowship
CCMB PhD Program Admission January 2022 - Download Biotecnika App to Apply
CCMB PhD Admissions 2022 January...
Did You Know These 🤔 Top 10 Untold Rules Of CSIR NET Life Science...
CSIR NET Exam Tips - How to Answer CSIR NET Life Sciences Paper
Hey guys whatsup, welcome to Biotecnika. Shekhar Suman here and today we...
Pepsi Food Technology Quality Executive Recruitment, Apply Online
Pepsi Food Technology Quality Executive Recruitment, Apply Online
Pepsi Food Technology Quality Executive Recruitment, Apply Online. PepsiCo India requires Food Technology to apply online for...
CCMB PhD Program Admission January 2022 – Online Application Process
CCMB PhD Admissions 2022 January - Apply Online
CCMB PhD Admissions 2022 January - Apply Online. Check out the eligibility for the CCMB - Centre...